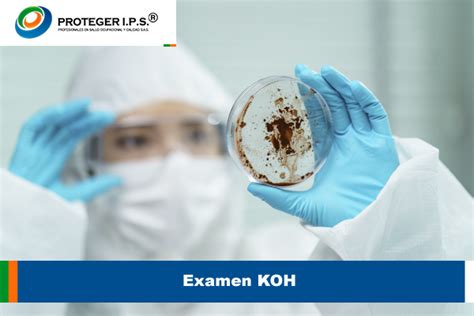

La dermatitis en la ingle es una inflamación de la piel que afecta la zona genital y los glúteos. Nuestra piel es una barrera natural que debemos cuidar.
La zona de la ingle es especialmente sensible, está poco ventilada y fisiológicamente está más predispuesta al roce, lo que en la mayoría de los casos conduce a enrojecimientos. En caso de detectar irritación en la zona íntima, es importante consultar con el médico, quien podrá valorar las causas y prescribir el tratamiento más adecuado.

¿Qué es la Tiña Inguinal?
La tiña inguinal (también llamada "tiña crural" o "prurito del atleta") es una infección fúngica, es decir, causada por hongos. El nombre de "prurito del atleta" se debe a que se ve a menudo en la gente activa que suda mucho mientras hace deporte. Pero cualquier persona puede contraer esta infección.
La tiña inguinal, también llamada tinea cruris o prurito del jockey, es una de las infecciones más comunes de la piel. La infección fúngica que acomete la región genital e inguinal se llama tinea cruris.
La tiña inguinal es un tipo de tiña que causa un salpullido con comezón en la piel de la zona de la ingle. Es mucho más común en los hombres que en las mujeres. La tiña no es causada por un gusano. Es causada por un hongo. Los tipos de hongos que causan la tiña viven y se propagan en la capa superior de la piel o en el cabello. La tiña es contagiosa.
Se propaga cuando usted tiene contacto piel a piel con una persona o con un animal que la tiene. Con frecuencia, las personas contraen tiña de la ingle ("tiña inguinal") al propagar accidentalmente el hongo del pie de atleta a la zona de su propia ingle.
Tengo manchas rojas en la ingle que pican / Tiña Inguinal | DR. DAVID CAMPOS
Causas de la Dermatitis Inguinal
La tiña inguinal está provocada por un hongo que prolifera en las zonas cálidas y húmedas del cuerpo. La tiña inguinal suele deberse al mismo organismo que causa el pie de atleta. El sarpullido puede contagiarse de una persona a otra por contacto de la piel o por compartir ropa o toallas contaminadas.
- Dermatitis irritativa por contacto: aparece tras el contacto repetido con sustancias irritantes. Generalmente se debe al uso de detergentes agresivos, perfumes con base alcohólica en el absorbente y contacto prolongado con orina y/o heces.
- Dermatitis por fricción: el ambiente húmedo de la ingle, combinado con el roce repetido del absorbente, puede causar enrojecimiento y posterior maceración de la piel.
El causante principal de la tiña crural es el hongo Trichophyton. Esta infección es más común en los hombres porque la humedad puede quedar atrapada entre el escroto y el muslo. La tiña crural se desarrolla con mayor frecuencia en climas cálidos o con el uso de ropa húmeda y apretada.
La gran mayoría de los casos de tiña inguinal es causada por el hongo Trichophyton rubrum, que puede ser un habitante normal de la piel, sin necesariamente provocar enfermedades, ya que nuestro sistema inmunológico consigue mantenerlo bajo control, desde que la piel se mantenga limpia y seca. El hongo Trichophyton rubrum, que provoca la tiña crural, es lo mismo que causa el pie de atleta.
No obstante, no basta tener contacto con el hongo para desarrollar micosis. Para que el microorganismo venza nuestro sistema inmunológico hay que encontrar un ambiente propicio para su multiplicación.
Factores de riesgo
- Fricción provocada por el hecho de llevar ropa demasiado ceñida (como trajes de baño) durante mucho tiempo seguido.
- No secarse bien la piel después de sudar, bañarse o nadar.

Síntomas de la Tiña Inguinal
Los principales síntomas de la tiña inguinal son picazón y rojez local (sarpullido). La tinea cruris generalmente empieza con algunas placas rojizas en la cara interna de uno o ambos muslos, con bordes bien demarcados. Cuando es causada por el hongo Trichophyton rubrum, la enfermedad generalmente se extiende por los muslos e incluso en el área púbica y las nalgas. En los hombres, el escroto y el pene por lo general no se ven afectados.
Los síntomas de tinea cruris incluyen una erupción pruriginosa, que puede ser dolorosa. La tiña crural causa un prurito bastante intenso y dolor. La erupción tiene un borde escamoso de color rosado. Por lo general, la afectación del escroto es mínima o nula.
La tiña de la piel puede comenzar como una zona pequeña de piel roja, escamosa o con comezón. A medida que la infección empeora, el patrón con forma de anillo y el color marrón rojizo pueden volverse más visibles. Si no se trata, la piel puede irritarse y doler.
Signos y Síntomas Comunes
- Parches rojos, levantados y descamativos que pueden formar ampollas y supurar. Las manchas a menudo tienen bordes muy definidos.
- Piel anormalmente oscura o clara. En ocasiones, estos cambios son permanentes.
- Enrojecimiento, descamación o formación de grietas en la piel de las áreas de la ingle, los muslos y las nalgas.
- La erupción puede tener un aspecto circular, de bordes bien definidos o incluso elevados (que sobresalen en la superficie de la piel).
- Puede picar, escocer o provocar ardor, o simplemente ser molesta e incómoda.
Diagnóstico de la Tiña Inguinal
Por lo general, el diagnóstico de tinea cruris resulta evidente para el médico después de la exploración física. Un médico te puede diagnosticar una tiña inguinal solo observándote la piel y preguntándote por tus síntomas y por tu estilo de vida.
Si el diagnóstico no resulta evidente, puede hacerse un raspado cutáneo y examinarlo al microscopio para confirmar que la erupción está causada por un hongo. Es posible que el médico te frote o raspe la piel para recoger una muestra de la parte escamada e infectada a fin de analizarla con un microscopio en el laboratorio.
El diagnóstico puede ser confirmado con raspado de la lesión y una evaluación microscópica del material buscando por hongos.
Pruebas Diagnósticas
- Exploración médica de la zona de la ingle
- Exploración de un raspado cutáneo
- Examen en hidróxido de potasio (KOH): Una simple prueba en el consultorio para buscar hongos.
- Cultivo de piel
- Biopsia de piel: Se puede llevar a cabo una biopsia de piel con un tinte especial llamado PAS para identificar hongos.
Tratamiento de la Tiña Inguinal
El tratamiento de la tiña crural consiste en una crema o loción antifúngica (como miconazol, naftifina, ketoconazol o clotrimazol). La micosis inguinal puede tratarse con ungüentos antifúngicos, muchos de los cuales se venden sin receta.
Los espráis, las cremas y los polvos antifúngicos (contra los hongos) de venta sin receta médica pueden resolver el problema si se trata de una tiña leve. Las infecciones más graves pueden requerir medicamentos de venta con receta médica, sea de tipo tópico (que se aplican sobre la piel) o en forma de pastilla.
Es posible que deba tomar pastillas antimicóticas (tratamiento oral) si la tiña no desaparece después de que usted haya probado diferentes antimicóticos tópicos o si la infección se extiende. El tratamiento suele incluir cremas o ungüentos antifúngicos como miconazol, ketoconazol, clotrimazol o terbinafina, recetados por un médico general o dermatólogo.
Opciones de Tratamiento
- Antimicóticos tópicos: Cremas o lociones que contienen miconazol, clotrimazol, terbinafina o tolnaftato.
- Antimicóticos orales: Medicamentos recetados como fluconazol o itraconazol para infecciones más severas.
- Alilaminas: Como terbinafina (Lamisil), disponibles en cremas, pastillas y geles.
- Azoles: Formas orales recetadas incluyen fluconazol (Diflucan) e itraconazol (Sporanox).
- Griseofulvina (Grifulvin V)
- Clotrimazol/betametasona (Lotrisone): Una combinación de antimicótico y de corticosteroide, se usa para tratar la tiña que causa ardor, comezón e inflamación.
Cuidados Personales y Remedios Caseros
- Mantenga la piel limpia y seca.
- No use ropa que frote o irrite la zona. Use ropa interior holgada.
- Lave los suspensorios a menudo.
- Evitar la humedad: es esencial cambiar el producto absorbente en cuanto se perciba que ha alcanzado su capacidad máxima, para evitar estar en contacto prolongado con la orina.
- Usar limpiadores específicos: se recomienda emplear limpiadores íntimos suaves, preferiblemente con pantenol y aceite de almendras por su efecto emoliente y nutritivo; o bien utilizar un limpiador sin enjuague como la espuma de limpieza Lindor®, formulada para una limpieza rápida, profunda y no agresiva con la piel. Su fórmula con creatinina ayuda al mecanismo natural de protección frente a agresiones externas.
- Aplicar una crema con óxido de zinc: junto con una higiene adecuada, es importante utilizar cremas con óxido de zinc para proteger y calmar la irritación.
Tabla de Tratamientos Comunes
| Tratamiento | Descripción | Uso |
|---|---|---|
| Miconazol | Crema antifúngica | Aplicación tópica para infecciones leves |
| Clotrimazol | Crema antifúngica | Aplicación tópica para infecciones leves |
| Terbinafina | Crema, gel o pastilla antifúngica | Infecciones moderadas a severas |
| Fluconazol | Pastilla antifúngica | Infecciones severas o persistentes |
Prevención de la Tiña Inguinal
La tiña inguinal se suele poder prevenir. Mantén la zona inguinal limpia y seca. Lávate todos los días y sécate por completo, sobre todo después de ducharte, bañarte, nadar o practicar actividades que te hagan sudar. Usa toallas limpias y evita compartir toallas. Lava los suspensorios deportivos lo más a menudo posible. Evita las prendas ajustadas.
Si tienes pie de atleta, sécate los pies con una toalla diferente. Ponte los calcetines antes que la ropa interior, para que parte de los hongos que contengan tus pies no acaben en tu ropa interior.
Medidas Preventivas
- Mantente seco: Seca el área de la ingle y la cara interna de los muslos con una toalla limpia después de ducharte o hacer ejercicio.
- Usa ropa limpia: Cámbiate la ropa interior al menos una vez al día o más a menudo si sudas mucho. Ayuda usar ropa interior de algodón u otra tela que respire y mantenga la piel más seca.
- Encuentra la ropa que te quede mejor: Elige ropa interior, suspensorios y uniformes deportivos que sean de tu talla. La ropa demasiado ajustada puede provocar rozaduras en la piel y aumentar el riesgo de tiña inguinal.
- No compartas los objetos personales: No dejes que otros usen tu ropa, tus toallas ni otros artículos personales.
- Trata o prevén el pie de atleta: Controla el pie de atleta para evitar que se disemine a la ingle.
tags: #dermatitis #en #region #inguinal